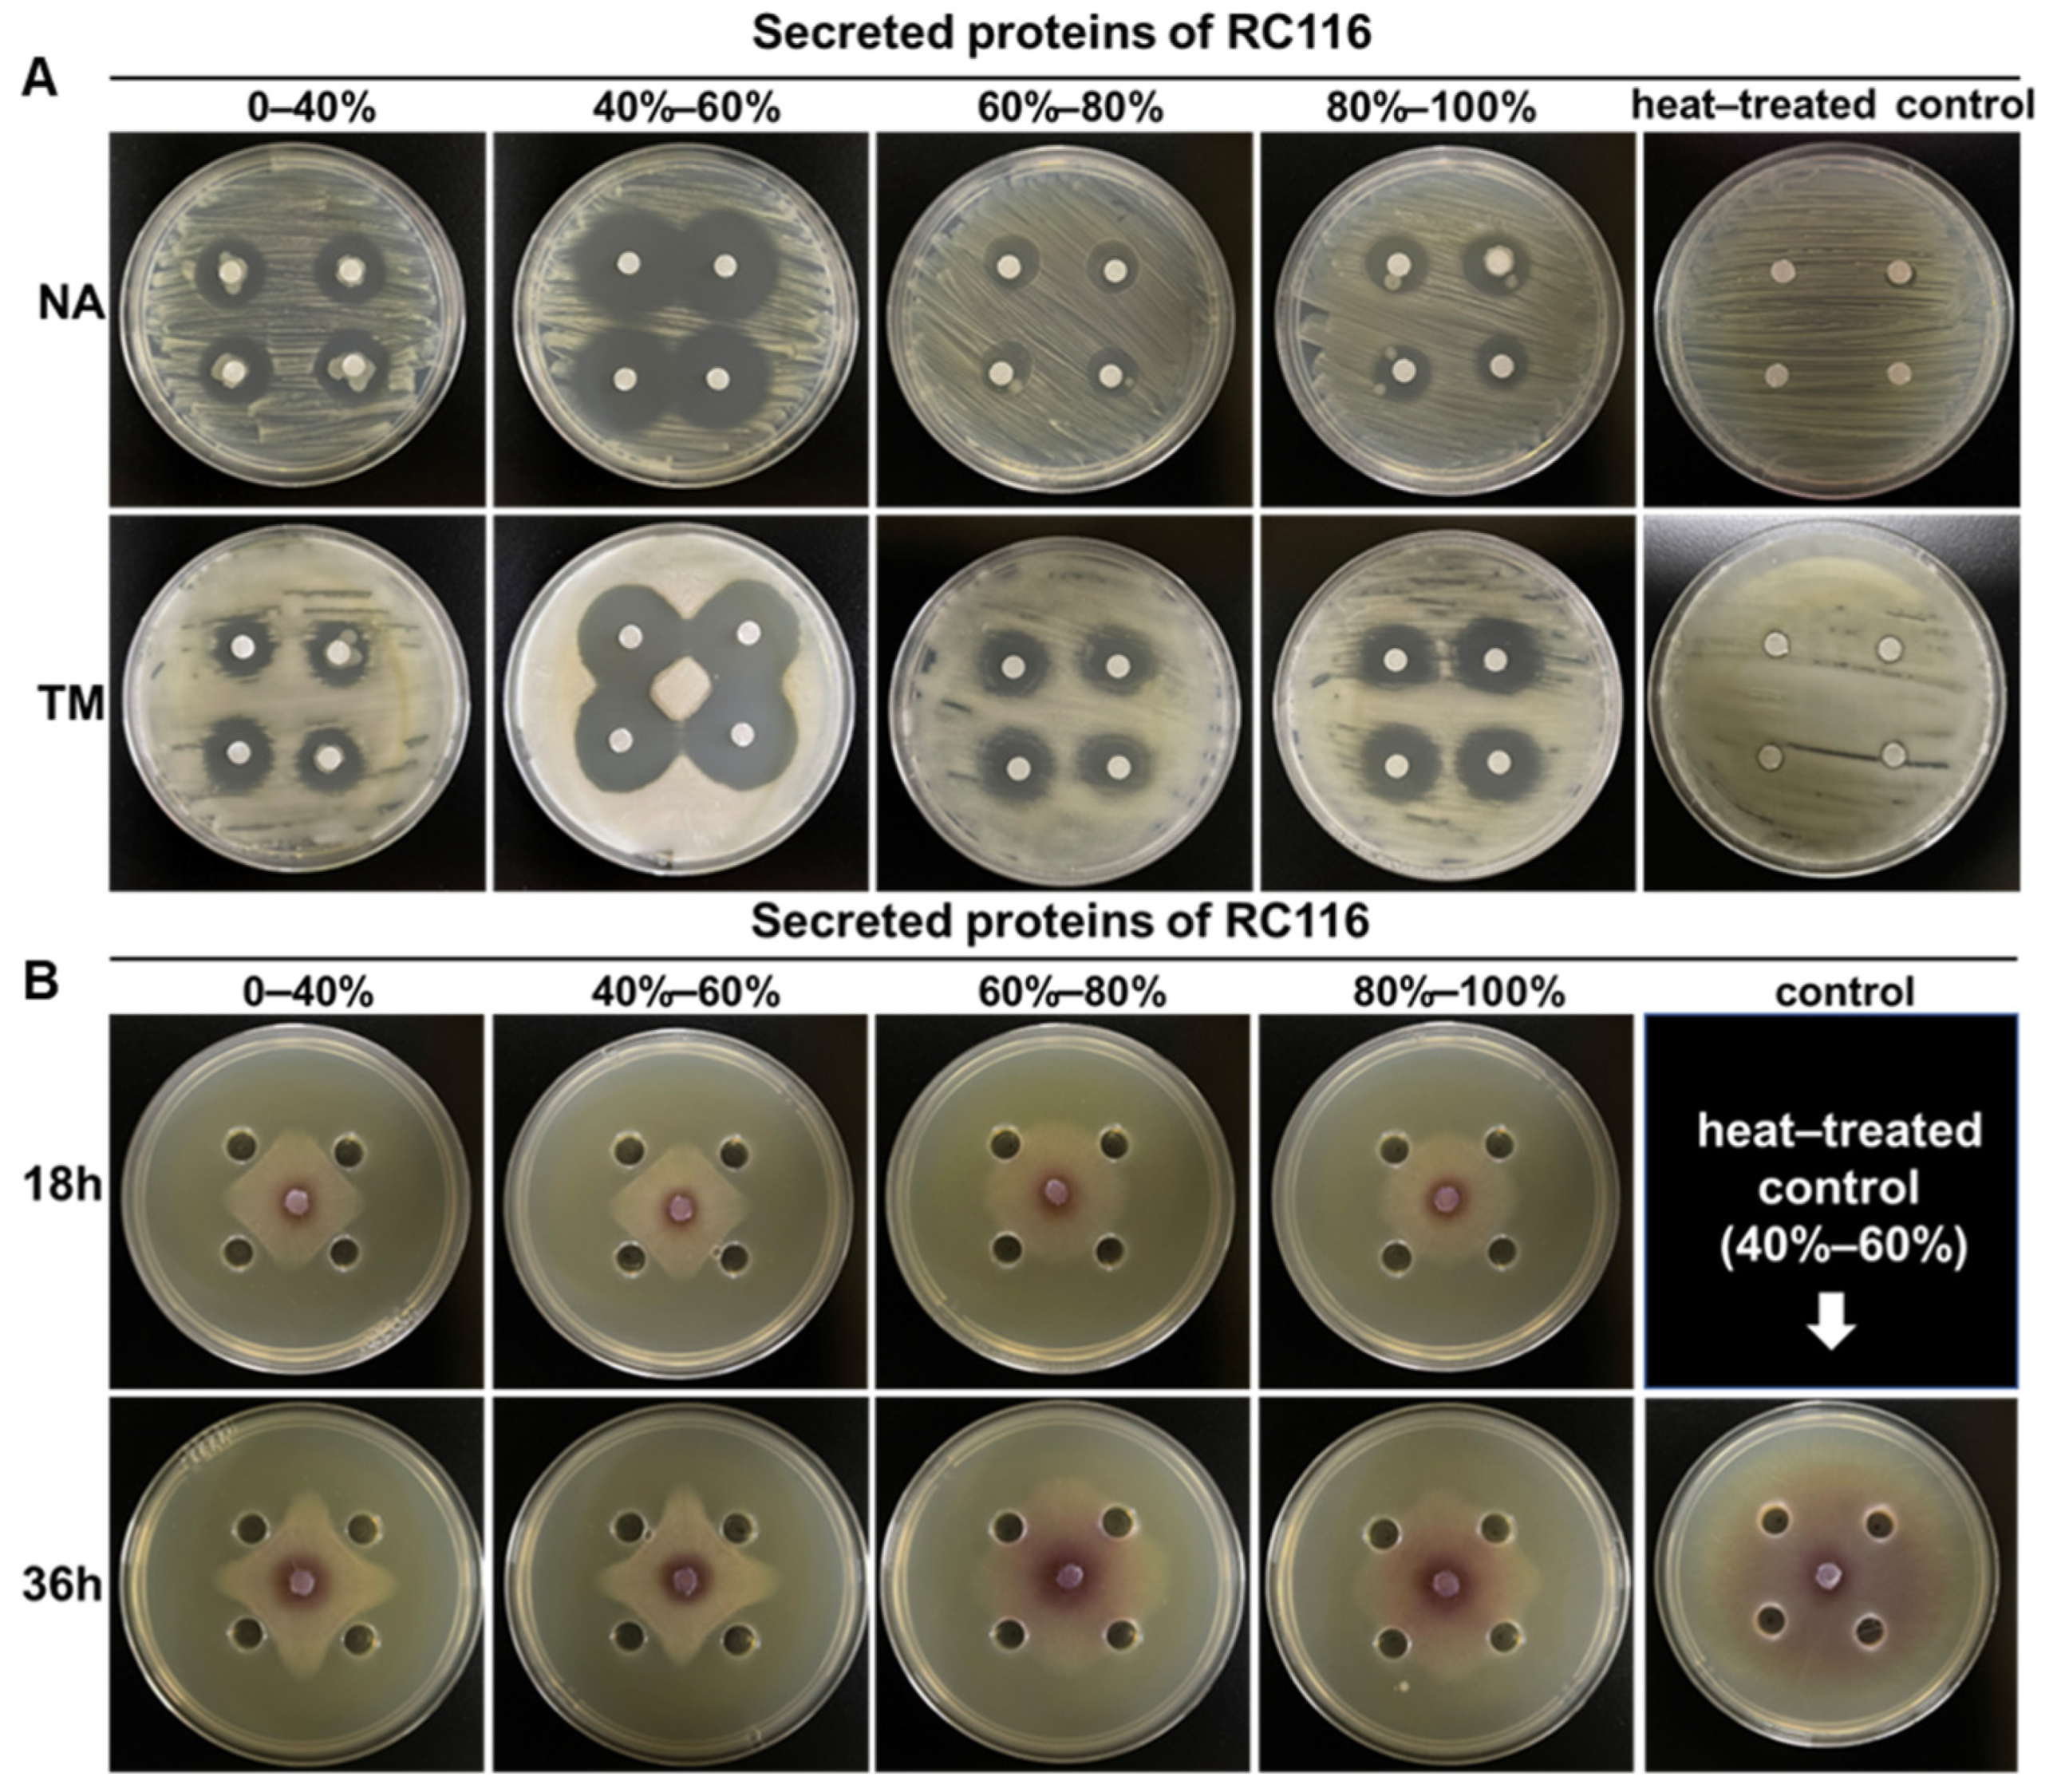

Bacillus velezensis RC116 Inhibits the Pathogens of Bacterial Wilt and Fusarium Wilt in Tomato with Multiple Biocontrol Traits
Abstract
1. Introduction
2. Results
2.1. Isolation and Screening of Rhizosphere Bacteria with Antibacterial Activity against Rs
2.2. RC116 with Broad-Spectrum Antimicrobial Activity Was Identified as B. velnzensis
2.3. RC116 and the Biocontrol Reference Strain FZB42 Show Stronger Antibacterial Activity Compared with Two Other B. velezensis Strains
2.4. Genome-Based Functional Annotation and Molecular Biology Assays Revealed the Antimicrobial Potential of RC116
2.5. Extracellular Enzymes of RC116 Exhibited Considerable Lytic Activity against Rs and Fol In Vitro
2.6. RC116 Exhibited High Biocontrol Efficacy against TBW and Promoted the Growth of Tomato Plantlets
3. Discussion
4. Materials and Methods
4.1. Antagonistic Bacteria and Plant Pathogens
4.2. Strain Isolation and Growth Conditions
4.3. Identification of RC116
4.4. DNA Extraction, Genome Sequencing, and Genome Assembly
4.5. Genome Function Annotation and Bioinformatic Analysis
4.6. Evaluation of the Ability of RC116 Antagonistic Plant Pathogens
4.7. Evaluation of the Biocontrol Efficacy and Growth-Promoting Effects of RC116 on TBW
4.8. Enzyme Productiony and Growth-Promoting Index of RC116
4.9. PCR Detection of Biocontrol-Related Genes in RC116
4.10. Activity of RC116 Extracellular Proteins against Rs and Fol
5. Conclusions
Supplementary Materials
Author Contributions
Funding
Institutional Review Board Statement
Informed Consent Statement
Data Availability Statement
Acknowledgments
Conflicts of Interest
References
- Nicola, S.; Tibaldi, G.; Fontana, E. Tomato production system and their application to the tropics. Acta Hortic. 2009, 821, 27–34. [Google Scholar] [CrossRef]
- Ajilogba, C.F.; Babalola, O.O. Integrated management strategies for tomato Fusarium wilt. Biocontrol Sci. 2013, 18, 117–127. [Google Scholar] [CrossRef]
- Li, M.; Pommier, T.; Yin, Y.; Wang, J.; Gu, S.; Jousset, A.; Keuskamp, J.; Wang, H.; Wei, Z.; Xu, Y.; et al. Indirect reduction of Ralstonia solanacearum via pathogen helper inhibition. ISME J. 2021, 16, 868–875. [Google Scholar] [CrossRef]
- Elanchezhiyan, K.; Keerthana, U.; Nagendran, K.; Prabhukarthikeyan, S.R.; Prabakar, K.; Raguchander, T.; Karthikeyan, G. Multifaceted benefits of Bacillus amyloliquefaciens strain FBZ24 in the management of wilt disease in tomato caused by Fusarium oxysporum f. sp. lycopersici. Physiol. Mol. Plant Pathol. 2018, 103, 92–101. [Google Scholar] [CrossRef]
- Liar, Y.; Nion, Y.A.; Toyota, K. Recent trends in control methods for bacterial wilt diseases caused by Ralstonia solanacearum. Microbes Environ. 2015, 30, 1–11. [Google Scholar] [CrossRef]
- Shen, T.; Lei, Y.; Pu, X.; Zhang, S.; Du, Y. Identification and application of Streptomyces microflavus G33 in compost to suppress tomato bacterial wilt disease. Appl. Soil Ecol. 2021, 157, 103724. [Google Scholar] [CrossRef]
- Ho, T.; Chiao-Yu, C.; Jing-Lin, Z.; Hong-Hua, C.; Liang, Y.; Huang, T.; Lina, Y. Bacillus amyloliquefaciens strain PMB05 intensifies plant immune responses to confer resistance against bacterial wilt of tomato. Phytopathology 2020, 12, 1877–1885. [Google Scholar] [CrossRef] [PubMed]
- Fan, H.; Li, S.; Zeng, L.; He, P.; Xu, S.; Bai, T.; Huang, Y.; Guo, Z.; Zheng, S. Biological control of Fusarium oxysporum f. sp. cubense tropical race 4 using natively isolated Bacillus spp. YN0904 and YN1419. J. Fungi 2021, 7, 795. [Google Scholar] [CrossRef]
- He, P.; Li, S.; Xu, S.; Fan, H.; Wang, Y.; Zhou, W.; Fu, G.; Han, G.; Wang, Y.; Zheng, S. Monitoring tritrophic biocontrol interactions between Bacillus spp., Fusarium oxysporum f. sp. cubense, tropical race 4, and banana plants in vivo based on fluorescent transformation system. Front. Microbiol. 2021, 12, 754918. [Google Scholar] [CrossRef]
- Ruiz-García, C.; Béjar, V.; Martínez-Checa, F.; Llamas, I.; Quesada, E. Bacillus velezensis sp. nov., a surfactant-producing bacterium isolated from the river Vélez in Málaga, southern Spain. Int. J. Syst. Evol. Micr. 2005, 55, 191–195. [Google Scholar] [CrossRef] [PubMed]
- Wang, L.T.; Lee, F.L.; Tai, C.J.; Kuo, H.P. Bacillus velezensis is a later heterotypic synonym of Bacillus amyloliquefaciens. Int. J. Syst. Evol. Micr. 2008, 58, 671–675. [Google Scholar] [CrossRef]
- Dunlap, C.A.; Kim, S.; Kwon, S.; Rooney, A.P. Bacillus velezensis is not a later heterotypic synonym of Bacillus amyloliquefaciens; Bacillus methylotrophicus, Bacillus amyloliquefaciens subsp. plantarum and ‘Bacillus oryzicola’ are later heterotypic synonyms of Bacillus velezensis based on phylogenomics. Int. J. Syst. Evol. Micr. 2016, 66, 1212–1217. [Google Scholar] [CrossRef]
- Huang, R.; Feng, H.; Xu, Z.; Zhang, N.; Liu, Y.; Shao, J.; Shen, Q.; Zhang, R. Identification of adhesins in plant beneficial rhizobacteria Bacillus velezensis SQR9 and their effect on root colonization. Mol. Plant Microbe Interact. 2022, 35, 64–72. [Google Scholar] [CrossRef] [PubMed]
- Chen, L.; Qu, Z.; Yu, W.; Zheng, L.; Qiao, H.; Wang, D.; Wei, B.; Zhao, Z. Complete genome sequence of Bacillus velezensis TH-1, a candidate biocontrol bacterium from China. Mol. Plant Microbe Interact. 2023. [Google Scholar] [CrossRef]
- Rabbee, M.; Ali, M.; Choi, J.; Hwang, B.; Jeong, S.; Baek, K. Bacillus velezensis: A valuable member of bioactive molecules within plant microbiomes. Molecules 2019, 24, 1046. [Google Scholar] [CrossRef] [PubMed]
- Gupta, R.K.; Fuke, P.; Khardenavis, A.A.; Purohit, H.J. In silico genomic characterization of Bacillus velezensis strain AAK_S6 for secondary metabolite and biocontrol potential. Curr. Microbiol. 2023, 80, 81. [Google Scholar] [CrossRef] [PubMed]
- Fan, B.; Wang, C.; Song, X.; Ding, X.; Wu, L.; Wu, H.; Gao, X.; Borriss, R. Bacillus velezensis FZB42 in 2018: The gram-positive model strain for plant growth promotion and biocontrol. Front. Microbiol. 2018, 9, 2491. [Google Scholar] [CrossRef]
- Schmiedeknecht, G.; Bochow, H.; Junge, H. Use of Bacillus subtilis as biocontrol agent. II. Biological control of potato diseases. Z. Pflanzenkrankh. Pflanzenschutz 1998, 105, 376–386. [Google Scholar]
- Sylla, J.; Alsanius, B.W.; Kruger, E.; Reineke, A.; Strohmeier, S.; Wohanka, W. Leaf microbiota of strawberries as affected by biological control agents. Phytopathology 2013, 103, 1001–1011. [Google Scholar] [CrossRef] [PubMed]
- Chowdhury, S.P.; Dietel, K.; Rändler, M.; Schmid, M.; Junge, H.; Borriss, R.; Hartmann, A.; Grosch, R.; van Overbeek, L. Effects of Bacillus amyloliquefaciens FZB42 on lettuce growth and health under pathogen pressure and its impact on the rhizosphere bacterial community. PLoS ONE 2013, 8, e68818. [Google Scholar] [CrossRef]
- Yao, A.V.; Bochow, H.; Karimov, S.; Boturov, U.; Sanginboy, S.; Sharipov, A.K. Effect of FZB 24®Bacillus subtilis as a biofertilizer on cotton yields in field tests. Arch. Phytopathol. Plant Prot. 2006, 39, 323–328. [Google Scholar] [CrossRef]
- Talboys, P.J.; Owen, D.W.; Healey, J.R.; Withers, P.J.; Jones, D.L. Auxin secretion by Bacillus amyloliquefaciens FZB42 both stimulates root exudation and limits phosphorus uptake in Triticum aestivum. BMC Plant Biol. 2014, 14, 51. [Google Scholar] [CrossRef] [PubMed]
- Vahidinasab, M.; Adiek, I.; Hosseini, B.; Akintayo, S.O.; Abrishamchi, B.; Pfannstiel, J.; Henkel, M.; Lilge, L.; Voegele, R.T.; Hausmann, R. Characterization of Bacillus velezensis UTB96, demonstrating improved lipopeptide production compared to the strain B. velezensis FZB42. Microorganisms 2022, 10, 2225. [Google Scholar] [CrossRef] [PubMed]
- Chen, L.; Heng, J.; Qin, S.; Bian, K. A comprehensive understanding of the biocontrol potential of Bacillus velezensis LM2303 against Fusarium head blight. PLoS ONE 2018, 13, e198560. [Google Scholar] [CrossRef] [PubMed]
- Choub, V.; Ajuna, H.B.; Won, S.; Moon, J.; Choi, S.; Maung, C.E.H.; Kim, C.; Ahn, Y.S. Antifungal activity of Bacillus velezensis CE 100 against anthracnose disease (Colletotrichum gloeosporioides) and growth promotion of walnut (Juglans regia L.) Trees. Int. J. Mol. Sci. 2021, 22, 10438. [Google Scholar] [CrossRef]
- Won, S.; Moon, J.; Ajuna, H.B.; Choi, S.; Maung, C.E.H.; Lee, S.; Ahn, Y.S. Biological control of leaf blight disease caused by Pestalotiopsis maculans and growth promotion of quercus acutissima carruth container seedlings using Bacillus velezensis CE 100. Int. J. Mol. Sci. 2021, 22, 11296. [Google Scholar] [CrossRef]
- Wang, W.; Kong, W.; Liao, Y.; Zhu, L. Identification of Bacillus velezensis SBB and its antifungal effects against Verticillium dahliae. J. Fungi 2022, 8, 1021. [Google Scholar] [CrossRef]
- Wang, B.; Yang, B.; Peng, H.; Lu, J.; Fu, P. Genome sequence and comparative analysis of fungal antagonistic strain Bacillus velezensis LJBV19. Folia Microbiol. 2022, 68, 73–86. [Google Scholar] [CrossRef]
- Pajčin, I.; Vlajkov, V.; Dodić, J.; Loc, M.; Grahovac, M.; Grahovac, J. Bacillus velezensis -biocontrol activity of cells and extracellular compounds against Xanthomonas spp. J. Process. Energy Agric. 2022, 26, 15–18. [Google Scholar] [CrossRef]
- Cao, Y.; Pi, H.; Chandrangsu, P.; Li, Y.; Wang, Y.; Zhou, H.; Xiong, H.; Helmann, J.D.; Cai, Y. Antagonism of two plant-growth promoting Bacillus velezensis isolates against Ralstonia solanacearum and Fusarium oxysporum. Sci. Rep. 2018, 8, 4360. [Google Scholar] [CrossRef]
- Chen, M.; Wang, J.; Liu, B.; Zhu, Y.; Xiao, R.; Yang, W.; Ge, C.; Chen, Z. Biocontrol of tomato bacterial wilt by the new strain Bacillus velezensis FJAT-46737 and its lipopeptides. BMC Microbiol. 2020, 20, 160. [Google Scholar] [CrossRef] [PubMed]
- Kumar, A.; Droby, S. Food Security and Plant Disease Management; Woodhead Publishing: Sawston, UK, 2021; pp. 19–35. [Google Scholar] [CrossRef]
- Ling, L.; Han, X.; Li, X.; Zhang, X.; Wang, H.; Zhang, L.; Cao, P.; Wu, Y.; Wang, X.; Zhao, J.; et al. A Streptomyces sp. NEAU-HV9: Isolation, identification, and potential as a biocontrol agent against Ralstonia solanacearum of tomato plants. Microorganisms 2020, 8, 351. [Google Scholar] [CrossRef] [PubMed]
- Wei, Z.; Yang, X.; Yin, S.; Shen, Q.; Ran, W.; Xu, Y. Efficacy of Bacillus-fortified organic fertiliser in controlling bacterial wilt of tomato in the field. Appl. Soil Ecol. 2011, 48, 152–159. [Google Scholar] [CrossRef]
- Xiong, H.; Li, Y.; Cai, Y.; Cao, Y.; Wang, Y. Isolation of Bacillus amyloliquefaciens JK6 and identification of its lipopeptides surfactin for suppressing tomato bacterial wilt. RSC Adv. 2015, 5, 82042–82049. [Google Scholar] [CrossRef]
- Kwon, J.W.; Kim, S.D. Characterization of an antibiotic produced by Bacillus subtilis JW-1 that suppresses Ralstonia solanacearum. J. Microbiol. Biotechn. 2014, 24, 13–18. [Google Scholar] [CrossRef]
- Im, S.M.; Yu, N.H.; Joen, H.W.; Kim, S.O.; Park, H.W.; Park, A.R.; Kim, J. Biological control of tomato bacterial wilt by oxydifficidin and difficidin-producing Bacillus methylotrophicus DR-08. Pestic. Biochem. Phys. 2020, 163, 130–137. [Google Scholar] [CrossRef]
- Hao, K.; He, P.; Blom, J.; Rueckert, C.; Mao, Z.; Wu, Y.; He, Y.; Borriss, R. The genome of plant growth-promoting Bacillus amyloliquefaciens subsp. plantarum strain YAU B9601-Y2 contains a gene cluster for mersacidin synthesis. J. Bacteriol. 2012, 194, 3264–3265. [Google Scholar] [CrossRef]
- RégineMaget-Danaa; Peypouxb, F. Lipopeptides: Biological and physicochemical properties pore-forming. Toxicology 1994, 87, 151–174. [Google Scholar] [CrossRef]
- Deleu, M.; Lorent, J.; Lins, L.; Brasseur, R.; Braun, N.; El Kirat, K.; Nylander, T.; Dufrêne, Y.F.; Mingeot-Leclercq, M.P. Effects of surfactin on membrane models displaying lipid phase separation. Biochim. Et Biophys. Acta (BBA)—Biomembr. 2013, 1828, 801–815. [Google Scholar] [CrossRef]
- Wu, L.; Wu, H.; Chen, L.; Yu, X.; Borriss, R.; Gao, X. Difficidin and bacilysin from Bacillus amyloliquefaciens FZB42 have antibacterial activity against Xanthomonas oryzae rice pathogens. Sci. Rep. 2015, 5, 12975. [Google Scholar] [CrossRef]
- Gu, X.; Zeng, Q.; Wang, Y.; Li, J.; Zhao, Y.; Li, Y.; Wang, Q. Comprehensive genomic analysis of Bacillus subtilis 9407 reveals its biocontrol potential against bacterial fruit blotch. Phytopathol. Res. 2021, 3, 4. [Google Scholar] [CrossRef]
- Li, S.; He, P.; Fan, H.; Liu, L.; Yin, K.; Yang, B.; Li, Y.; Huang, S.; Li, X.; Zheng, S. A real-time fluorescent reverse transcription quantitative PCR assay for rapid detection of genetic markers’ expression associated with Fusarium wilt of banana biocontrol activities in Bacillus. J. Fungi 2021, 7, 353. [Google Scholar] [CrossRef] [PubMed]
- Li, H.; Luo, Y.; Zhang, X.; Shi, W.; Gong, Z.; Shi, M.; Chen, L.; Chen, X.; Zhang, Y.; Song, X. Trichokonins from Trichoderma pseudokoningii SMF2 induce resistance against Gram-negative Pectobacterium carotovorum subsp. Carotovorum in Chinese cabbage. FEMS Microbiol. Lett. 2014, 354, 75–82. [Google Scholar] [CrossRef] [PubMed]
- Weisburg, W.G.; Barns, S.M.; Pelletier, D.A.; Lane, D.J. 16S ribosomal DNA amplification for phylogenetic study. J. Bacteriol. 1991, 173, 697–703. [Google Scholar] [CrossRef]
- Dong, H.; Xu, X.; Gao, R.; Li, Y.; Li, A.; Yao, Q.; Zhu, H. Myxococcus xanthus R31 suppresses tomato bacterial wilt by inhibiting the pathogen Ralstonia solanacearum with secreted proteins. Front. Microbiol. 2022, 12, 801091. [Google Scholar] [CrossRef]
- Yoon, S.; Ha, S.; Kwon, S.; Lim, J.; Kim, Y.; Seo, H.; Chun, J. Introducing EzBioCloud: A taxonomically united database of 16S rRNA gene sequences and whole-genome assemblies. Int. J. Syst. Evol. Micr. 2017, 67, 1613–1617. [Google Scholar] [CrossRef]
- Tamura, K.; Stecher, G.; Kumar, S. MEGA11: Molecular evolutionary genetics analysis version 11. Mol. Biol. Evol. 2021, 38, 3022–3027. [Google Scholar] [CrossRef]
- Bankevich, A.; Nurk, S.; Antipov, D.; Gurevich, A.A.; Dvorkin, M.; Kulikov, A.S.; Lesin, V.M.; Nikolenko, S.I.; Pham, S.; Prjibelski, A.D.; et al. SPAdes: A new genome assembly algorithm and its applications to single-cell sequencing. J. Comput. Biol. 2012, 19, 455–477. [Google Scholar] [CrossRef]
- Parks, D.H.; Imelfort, M.; Skennerton, C.T.; Hugenholtz, P.; Tyson, G.W. CheckM: Assessing the quality of microbial genomes recovered from isolates, single cells, and metagenomes. Genome Res. 2015, 25, 1043–1055. [Google Scholar] [CrossRef]
- Seemann, T. Prokka: Rapid prokaryotic genome annotation. Bioinformatics 2014, 30, 2068–2069. [Google Scholar] [CrossRef]
- Aziz, R.K.; Bartels, D.; Best, A.A.; DeJongh, M.; Disz, T.; Edwards, R.A.; Formsma, K.; Gerdes, S.; Glass, E.M.; Kubal, M.; et al. The RAST Server: Rapid annotations using subsystems technology. BMC Genom. 2008, 9, 75. [Google Scholar] [CrossRef] [PubMed]
- Na, S.; Kim, Y.O.; Yoon, S.; Ha, S.; Baek, I.; Chun, J. UBCG: Up-to-date bacterial core gene set and pipeline for phylogenomic tree reconstruction. J. Microbiol. 2018, 56, 280–285. [Google Scholar] [CrossRef] [PubMed]
- Jain, C.; Rodriguez-R, L.M.; Phillippy, A.M.; Konstantinidis, K.T.; Aluru, S. High throughput ANI analysis of 90K prokaryotic genomes reveals clear species boundaries. Nat. Commun. 2018, 9, 5114. [Google Scholar] [CrossRef]
- Meier-Kolthoff, J.P.; Auch, A.F.; Klenk, H.P.; Goker, M. Genome sequence-based species delimitation with confidence intervals and improved distance functions. BMC Bioinform. 2013, 14, 60. [Google Scholar] [CrossRef] [PubMed]
- Zhang, H.; Yohe, T.; Huang, L.; Entwistle, S.; Wu, P.; Yang, Z.; Busk, P.K.; Xu, Y.; Yin, Y. dbCAN2: A meta server for automated carbohydrate-active enzyme annotation. Nucleic Acids Res. 2018, 46, W95–W101. [Google Scholar] [CrossRef]
- Lombard, V.; Golaconda Ramulu, H.; Drula, E.; Coutinho, P.M.; Henrissat, B. The carbohydrate-active enzymes database (CAZy) in 2013. Nucleic Acids Res. 2013, 42, D490–D495. [Google Scholar] [CrossRef]
- Rawlings, N.D.; Waller, M.; Barrett, A.J.; Bateman, A. MEROPS: The database of proteolytic enzymes, their substrates and inhibitors. Nucleic Acids Res. 2013, 42, D503–D509. [Google Scholar] [CrossRef] [PubMed]
- Blin, K.; Shaw, S.; Kloosterman, A.M.; Charlop-Powers, Z.; van Wezel, G.P.; Medema, M.H.; Weber, T. antiSMASH 6.0: Improving cluster detection and comparison capabilities. Nucleic Acids Res. 2021, 49, W29–W35. [Google Scholar] [CrossRef] [PubMed]
- Popoola, A.R.; Ganiyu, S.A.; Enikuomehin, O.A.; Bodunde, J.G.; Adedibu, O.B.; Durosomo, H.A.; Karunwi, O.A. Isolation and characterization of Ralstonia solanacearum causing bacterial wilt of tomato in Nigeria. Niger. J. Biotechnol. 2015, 29, 1–10. [Google Scholar] [CrossRef]
- Wang, G.; Kong, J.; Cui, D.; Zhao, H.; Niu, Y.; Xu, M.; Jiang, G.; Zhao, Y.; Wang, W. Resistance against Ralstonia solanacearum in tomato depends on the methionine cycle and the γ-aminobutyric acid metabolic pathway. Plant J. 2019, 97, 1032–1047. [Google Scholar] [CrossRef]
- Wang, Y.; Huang, W.; Ali, S.W.; Li, Y.; Yu, F.; Deng, H. Isolation, Identification, and characterization of an efficient siderophore producing bacterium from heavy metal contaminated soil. Curr. Microbiol. 2022, 79, 227. [Google Scholar] [CrossRef] [PubMed]
- Subramanium, N.; Sundaram, L. Siderophore producing Pseudomonas spp. isolated from rhizospheric soil and enhancing iron content in Arachis hypogaea L. plant. J. Agric. Technol. 2020, 16, 429–442. [Google Scholar]
- Mora, I.; Cabrefiga, J.; Montesinos, E. Antimicrobial peptide genes in Bacillus strains from plant environments. Int. Microbiol. 2011, 14, 213–223. [Google Scholar] [CrossRef] [PubMed]
- Joshi, R.; McSpadden, G.B. Identification and characterization of novel genetic markers associated with biological control activities in Bacillus subtilis. Phytopathology 2006, 96, 145–154. [Google Scholar] [CrossRef]
- Qadrie, Z.L.; Jacob, B.; Anandan, R.; Rajkapoor, B.; Rahamathulla, M. Anti-bacterial activity of ethanolic extract of Indoneesiella echioides (L) nees. evaluated by the filter paper disc method. Pak. J. Pharm. Sci. 2009, 22, 123–125. [Google Scholar]

| API 20NE | RC116 | API ZYM | RC116 |
|---|---|---|---|
| Reduction of nitrate to nitrite | + | Control | |
| Denitrification | − | Alkaline phosphatase | + |
| Indole production | − | Esterase (C4) | + |
| D-glucose fermentation | − | Esterase lipase (C8) | + |
| Arginine dihydrolase | − | Lipase (C14) | + |
| Urease | w | Leucine arylamidase | − |
| β-glucosidase (aesculin hydrolysis) | + | Valine arylamidase | − |
| Gelatin hydrolysis | + | Cystine arylamidase | − |
| D-glucose | + | Trypsin | − |
| L-arabinose | + | α-chymotrypsin | − |
| D-mannose | + | Acid phosphatase | + |
| D-mannitol | + | Napthol-AS-BI-phosphohydrolase | + |
| N-acetyl-glucosamine | + | α-galactosidase | − |
| D-maltose | + | β-galactosidase | − |
| Potassium gluconate | w | β-glucuronidase | − |
| Capric acid | − | α-glucosidase | + |
| Adipic acid | w | β-glucosidase | + |
| Malic acid | + | N-acetyl-β-glucosaminidase | − |
| Trisodium citrate | + | α-mannosidase | − |
| Phenylacetic acid | w | α-fucosidase | − |
| Genomic Features | RC116 |
|---|---|
| Size (bp) | 4,020,633 |
| Contigs numbers | 168 |
| DNA G + C content (%) | 46.5 |
| The longest contigs (bp) | 2,162,881 |
| Contigs N50 (bp) | 2,162,881 |
| L 50 value | 1 |
| Number of genes | 4044 |
| Number of CDS * | 3793 |
| Number of rRNA genes | 13 |
| Number of tRNA genes | 85 |
| Completeness (%) | 99.81 |
| Contamination | 0.72 |
| GenBank accession number | JAJJMX010000001 |
| Bacillus velezensis RC116 | Presence (+) or Absence (−) | ||||
|---|---|---|---|---|---|
| Gene Clusters | Region | Types | Most Similar Known Clusters | Similarity | FZB 42 |
| Scaffold 1 | 1.1 | PKS-like 1 | butirosin A/butirosin B | 7% | + |
| 1.2 | terpene | unkonwn | − | + | |
| 1.3 | transAT-PKS, T3PKS 2, NRPS 3 | kalimantacin A | 17% | − | |
| 1.4 | transAT-PKS | macrolactin H | 100% | + | |
| 1.5 | transAT-PKS, T3PKS, NRPS | bacillaene | 100% | + | |
| 1.6 | NRPS, transAT-PKS, betalactone 4 | fengycin | 100% | + | |
| 1.7 | terpene | unknown | − | + | |
| 1.8 | T3PKS | micrococcin P1 | 8% | − | |
| 1.9 | transAT-PKS | difficidin | 100% | + | |
| Scaffold 2 | 2.1 | NRPS, Ripp-like 5 | bacillibactin | 100% | + |
| 2.2 | Other 6 | baciysin | 100% | + | |
| Scaffold 3 | 3.1 | NRPS | surfactin | 91% | + |
| Scaffold 4 | 4.1 | LAP, RRE-containing 7 | plantazolicin | 91% | + |
Disclaimer/Publisher’s Note: The statements, opinions and data contained in all publications are solely those of the individual author(s) and contributor(s) and not of MDPI and/or the editor(s). MDPI and/or the editor(s) disclaim responsibility for any injury to people or property resulting from any ideas, methods, instructions or products referred to in the content. |
© 2023 by the authors. Licensee MDPI, Basel, Switzerland. This article is an open access article distributed under the terms and conditions of the Creative Commons Attribution (CC BY) license (https://creativecommons.org/licenses/by/4.0/).
Share and Cite
Dong, H.; Gao, R.; Dong, Y.; Yao, Q.; Zhu, H. Bacillus velezensis RC116 Inhibits the Pathogens of Bacterial Wilt and Fusarium Wilt in Tomato with Multiple Biocontrol Traits. Int. J. Mol. Sci. 2023, 24, 8527. https://doi.org/10.3390/ijms24108527
Dong H, Gao R, Dong Y, Yao Q, Zhu H. Bacillus velezensis RC116 Inhibits the Pathogens of Bacterial Wilt and Fusarium Wilt in Tomato with Multiple Biocontrol Traits. International Journal of Molecular Sciences. 2023; 24(10):8527. https://doi.org/10.3390/ijms24108527
Chicago/Turabian StyleDong, Honghong, Ruixiang Gao, Yijie Dong, Qing Yao, and Honghui Zhu. 2023. "Bacillus velezensis RC116 Inhibits the Pathogens of Bacterial Wilt and Fusarium Wilt in Tomato with Multiple Biocontrol Traits" International Journal of Molecular Sciences 24, no. 10: 8527. https://doi.org/10.3390/ijms24108527
APA StyleDong, H., Gao, R., Dong, Y., Yao, Q., & Zhu, H. (2023). Bacillus velezensis RC116 Inhibits the Pathogens of Bacterial Wilt and Fusarium Wilt in Tomato with Multiple Biocontrol Traits. International Journal of Molecular Sciences, 24(10), 8527. https://doi.org/10.3390/ijms24108527

